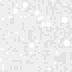

Mars Pathfinder IMP Image I882629L.IMG
COMMAND SEQUENCE #156: NIGHTTIME OPACITY 2

Click to download full resolution PDS image:
sky/seq0156/c1247xxx/i882629l.img
|
|
|
|
PDS Label Parameters
|
|
|
|
| Product Id | IMP_EDR-1247882629-REGULAR-0156020002 | ||
| Target Name | SKY | Instrument Deployment State | DEPLOYED |
| Image Time | 1997-07-18T02:03:44.303Z | Azimuth Motor Clicks | 55 |
| Planet Day Number | 14 | Elevation Motor Clicks | 294 |
| MPF Local Time | 03:32:11 | Instrument Azimuth | 179.8870 |
| Frame ID | LEFT | Instrument Elevation | 66.4975 |
| Exposure Duration | 32767.0000 | Surface Based Inst. Azimuth | 344.6060 |
| Filter Name | L670_R670 | Surface Based Inst. Elevation | 66.3322 |
| Filter Number | 5 | Solar Azimuth | 63.0798 |
| Inst. Cmprs. Ratio | 27.7714 | Solar Elevation | -28.9434 |
| Observation Name | NIGHTTIME_OPACITY_2.4CMD | ||